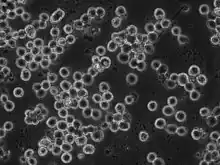

Sf9 (cells)
Phase contrast image of SF9 cells
Sf9 cells, a clonal isolate of Spodoptera frugiperda Sf21 cells (IPLB-Sf21-AE), are commonly used in insect cell culture for recombinant protein production using baculovirus. They were originally established from ovarian tissue.[1] They can be grown in the absence of serum, and can be cultured attached or in suspension.[2]
Sf9 Rhabdovirus
It has previously been shown that some Sf9 cell lines harbor a negative sense Rhabdovirus called Spodoptera frugiperda rhabdovirus (SfRV).[3][4] However, not all tested Sf9 cells appear to be infected with this virus.[5] SfRV appears to be insect-specific and does not appear to infect mammalian cell lines.[6]
References
- ↑ Vaughn JL; Goodwin RH; Tompkins GJ; McCawley P (1977). "The establishment of two cell lines from the insect Spodoptera frugiperda (Lepidoptera; Noctuidae)". In Vitro. 13 (4): 213–217. doi:10.1007/BF02615077. PMID 68913. S2CID 13529129.
- ↑ Invitrogen (14 Mar 2017). "Cell Lines". Growth and Maintenance of Insect cell lines: User Guide (PDF). Rev. Date - 8 March 2010. Invitrogen. Manual part no. 25-0127, MAN0000030. Retrieved 12 May 2017.
- ↑ Ma H, Galvin TA, Glasner DR, Shaheduzzaman S, Khan AS (2014). "Identification of a novel rhabdovirus in Spodoptera frugiperda cell lines". J Virol. 88 (12): 6576–85. doi:10.1128/JVI.00780-14. PMC 4054387. PMID 24672045.
{{cite journal}}: CS1 maint: multiple names: authors list (link) - ↑ Parry R, de Malmanche H, Asgari S (2021). "Persistent Spodoptera frugiperda rhabdovirus infection in Sf9 cells is not restricted by Wolbachia wMelPop-CLA and wAlbB strains and is targeted by the RNAi machinery". Virology. 563: 82–87. doi:10.1016/j.virol.2021.08.013. PMID 34492433.
{{cite journal}}: CS1 maint: multiple names: authors list (link) - ↑ Hashimoto Y, Macri D, Srivastava I, McPherson C, Felberbaum R, Post P; et al. (2017). "Complete study demonstrating the absence of rhabdovirus in a distinct Sf9 cell line". PLOS ONE. 12 (4): e0175633. Bibcode:2017PLoSO..1275633H. doi:10.1371/journal.pone.0175633. PMC 5397025. PMID 28423032.
{{cite journal}}: CS1 maint: multiple names: authors list (link) - ↑ Maghodia AB, Jarvis DL (2017). "Infectivity of Sf-rhabdovirus variants in insect and mammalian cell lines". Virology. 512: 234–245. doi:10.1016/j.virol.2017.09.025. PMC 5651996. PMID 29024851.
External links
This article is issued from Wikipedia. The text is licensed under Creative Commons - Attribution - Sharealike. Additional terms may apply for the media files.